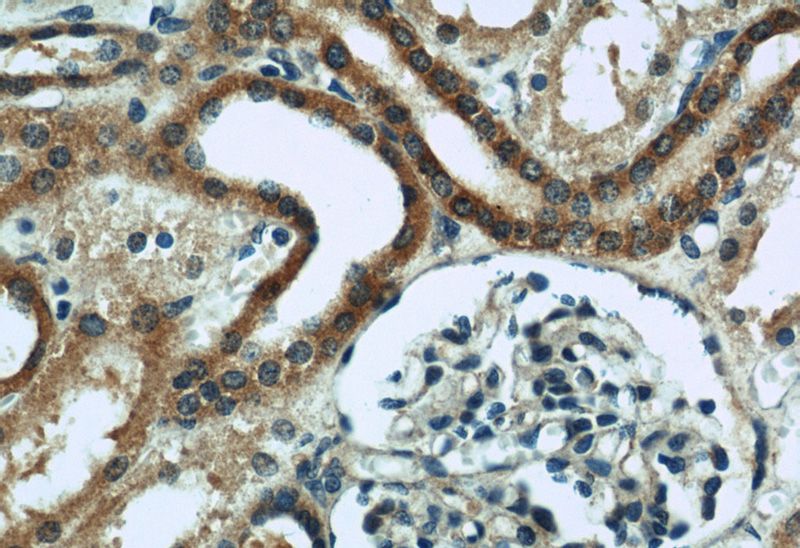
Immunohistochemical of paraffin-embedded human kidney using Catalog No:117045(ZFYVE16 antibody) at dilution of 1:200 (under 40x lens)
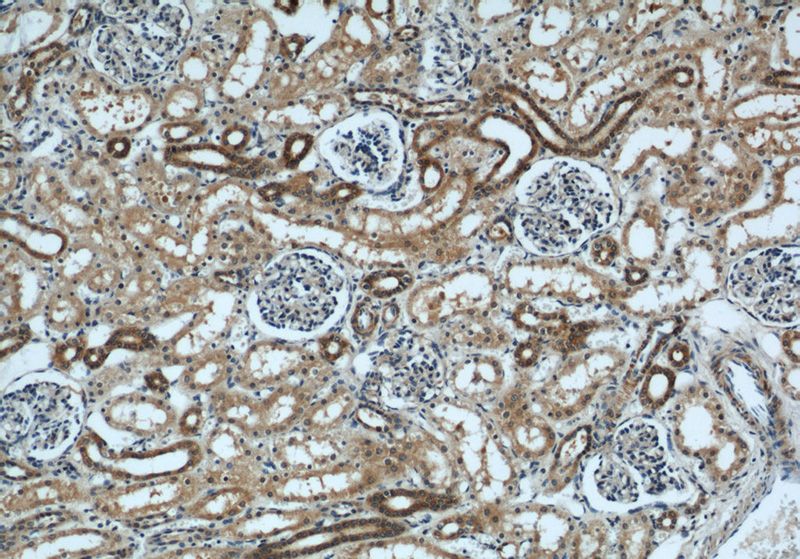
Immunohistochemical of paraffin-embedded human kidney using Catalog No:117045(ZFYVE16 antibody) at dilution of 1:200 (under 10x lens)

-
Product Name
ZFYVE16 antibody
- Documents
-
Description
ZFYVE16 Rabbit Polyclonal antibody. Positive IF detected in HeLa cells. Positive IHC detected in human kidney tissue, human heart tissue, human placenta tissue. Positive WB detected in MDA-MB-453s cells, HEK-293 cells, HeLa cells, human placenta tissue, mouse kidney tissue. Positive IP detected in HeLa cells. Observed molecular weight by Western-blot: 169 kDa,250 kDa
-
Tested applications
ELISA, WB, IP, IHC, IF
-
Species reactivity
Human,Mouse,Rat; other species not tested.
-
Alternative names
DKFZp686E13162 antibody; ENDOFIN antibody; KIAA0305 antibody; ZFYVE16 antibody
-
Isotype
Rabbit IgG
-
Preparation
This antibody was obtained by immunization of ZFYVE16 recombinant protein (Accession Number: BC032227). Purification method: Antigen affinity purified.
-
Clonality
Polyclonal
-
Formulation
PBS with 0.02% sodium azide and 50% glycerol pH 7.3.
-
Storage instructions
Store at -20℃. DO NOT ALIQUOT
-
Applications
Recommended Dilution:
WB: 1:500-1:5000
IP: 1:200-1:2000
IHC: 1:20-1:200
IF: 1:20-1:200
-
Validations

MDA-MB-453s cells were subjected to SDS PAGE followed by western blot with Catalog No:117045(ZFYVE16 antibody) at dilution of 1:400

Immunofluorescent analysis of HeLa cells using Catalog No:117045(ZFYVE16 Antibody) at dilution of 1:50 and Alexa Fluor 488-congugated AffiniPure Goat Anti-Rabbit IgG(H+L)

IP Result of anti-ZFYVE16 (IP:Catalog No:117045, 5ug; Detection:Catalog No:117045 1:500) with HeLa cells lysate 2000ug.
Immunohistochemical of paraffin-embedded human kidney using Catalog No:117045(ZFYVE16 antibody) at dilution of 1:200 (under 40x lens)
Immunohistochemical of paraffin-embedded human kidney using Catalog No:117045(ZFYVE16 antibody) at dilution of 1:200 (under 10x lens)
-
Background
Endofin (also known as ZFYVE16) is an endosomal FYVE domian protein implicated in regulating membrane trafficking. Endofin has been shown to localize to early endosomes. It co-localizes with SARA but does not associate with it or Smad2 and does not behave like SARA in affecting TGF-signaling. Northern blot analysis showed ZFYVE16 was widely expressed with high levels in kidney, placenta and lung. Overexpression of Endofin causes endosome aggregation. The gene of ZFYVE16 maps to chromosome 5q14, and encodes a 1539-amino acid protein with a molecular mass of 169 kDa. In addition, endogenous Endofin can also be detected as a band of 230-250 kDa. (PMID: 11546807)
-
References
- Bakkebø M, Huse K, Hilden VI. SARA is dispensable for functional TGF-β signaling. FEBS letters. 586(19):3367-72. 2012.
- Oltrabella F, Pietka G, Ramirez IB. The Lowe syndrome protein OCRL1 is required for endocytosis in the zebrafish pronephric tubule. PLoS genetics. 11(4):e1005058. 2015.
Related Products / Services
Please note: All products are "FOR RESEARCH USE ONLY AND ARE NOT INTENDED FOR DIAGNOSTIC OR THERAPEUTIC USE"
